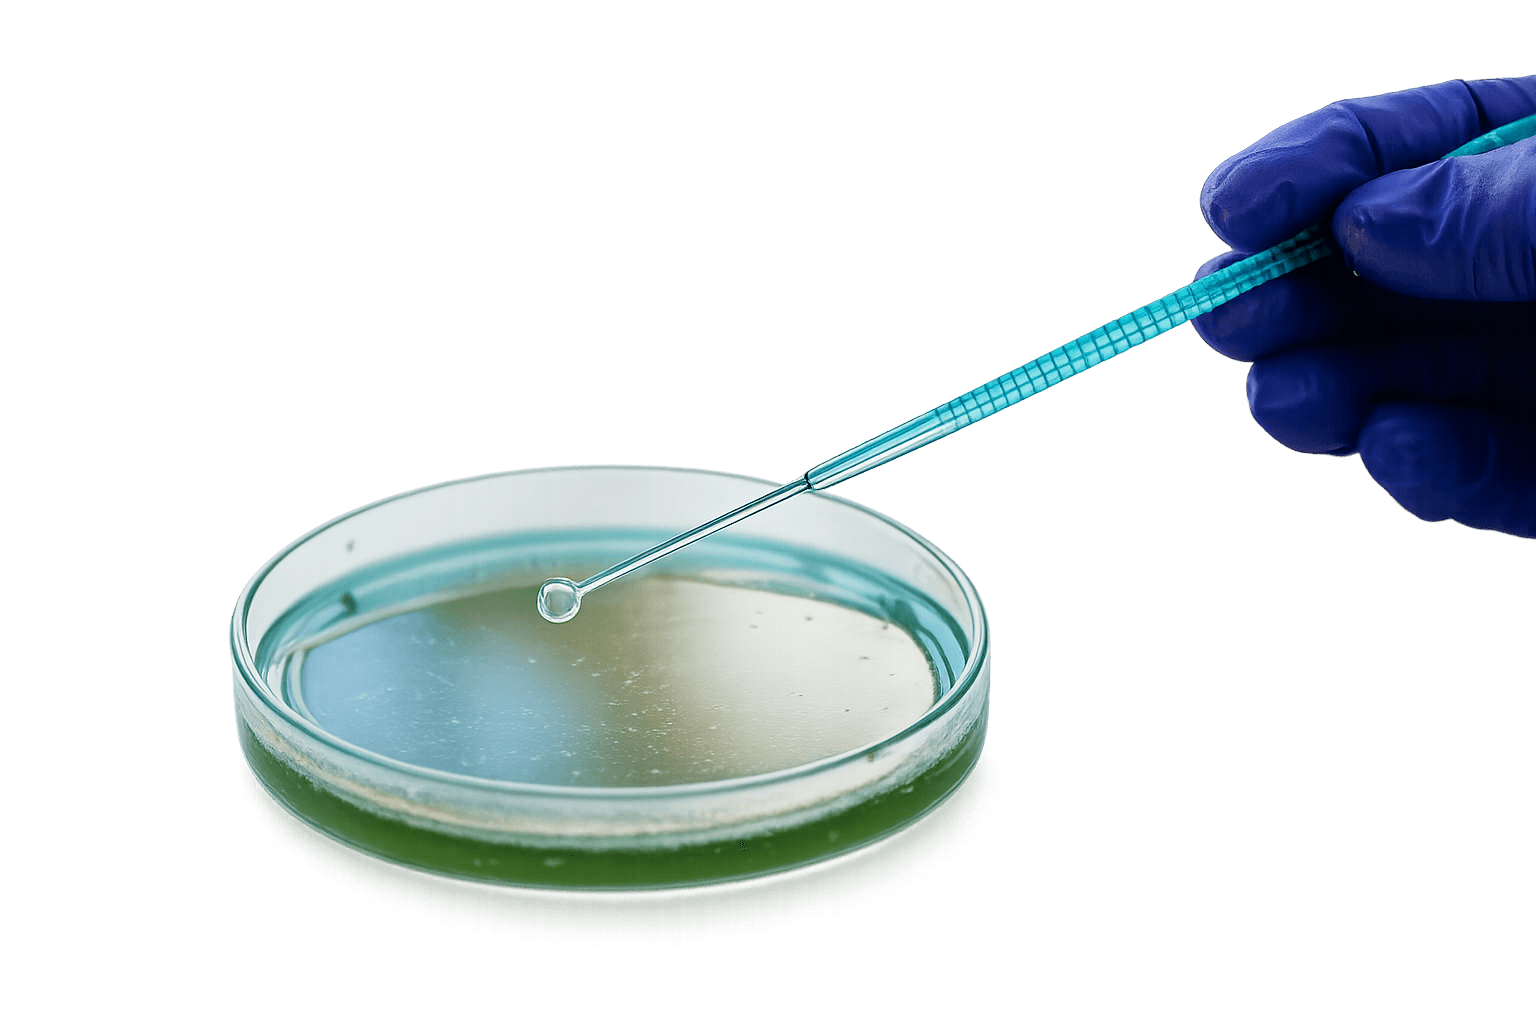
Inoculation & Culture

Reg. office
Pragathy Buldg, KINFRA Industrial park, Kinfra PO, Koratty Thrissur dist.Kerala INDIA -680309
Astra Bioscience delivers innovative laboratory products and scientific solutions supporting research, diagnostics, and healthcare advancements with quality and reliability.
Years of Expertise
Happy Clients
Cutting-edge products that redefine quality, performance, and reliability.
Committed in providing reliable high-quality products to meet international standards.
Supporting laboratories and institutions with dependable products, expertise, and long-term collaboration.
Discover our product portfolio and capabilities in one comprehensive guide.
Download BrochureJoin hundreds of satisfied customers who rely on our innovative solutions to achieve their goals.






























































Products aligned with industry regulations and benchmarks.
Comprehensive solutions for diverse healthcare needs.
Quick assistance and effective communication
Quality assurance and trusted expertise to research institutions, hospitals and laboratories worldwide.
Committed to the highest industry standards of quality, safety, and scientific excellence.




Our dedicated team across different regions are ready to assist you.
Pragathy Buldg, KINFRA Industrial park, Kinfra PO, Koratty Thrissur dist.Kerala INDIA -680309
Plot No.4, KINFRA Industrial Park, Kinfra PO, Koratty, Thrissur dist., INDIA-680309
SDF III/F/5, KINFRA Industrial Park, Kinfra PO, Koratty, Thrissur dist.,INDIA-680309
III/644/J, KINFRA Industrial Park, Kinfra PO, Koratty, Thrissur dist.,INDIA-680309